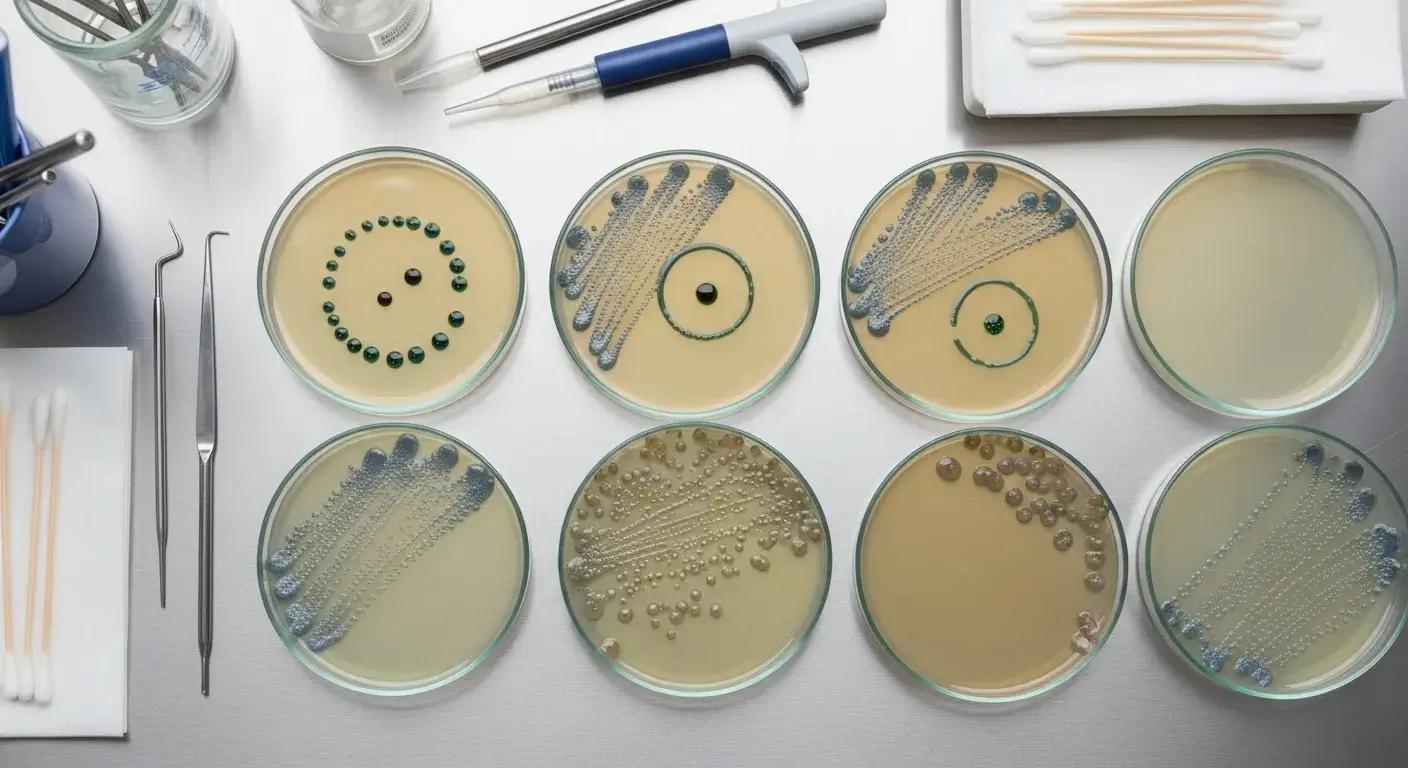
Tea tree oil lab results Petri dishes showing antimicrobial effects of tea tree oil

Skin infections, acne, and fungal issues frustrate millions. Chemical treatments often cause irritation. Tea tree oil offers natural antimicrobial power with proven results.
Tea tree oil is a pale yellow essential oil from Australian tea tree leaves. It kills bacteria and fungi naturally, making it effective for acne, athlete’s foot, and minor skin problems when diluted properly.
I’ve helped hundreds of customers choose the right tea tree oil at Phytoex. Let me share what actually works and what doesn’t, so you can use it safely and effectively.
Where Does Tea Tree Oil Actually Come From?
Many people think tea tree oil comes from regular tea plants. This confusion leads to wrong expectations about safety and uses. It’s from a completely different Australian tree with unique properties.
Tea tree oil comes from Melaleuca alternifolia trees1 in Australia. It has nothing to do with drinking tea. Australian Aboriginal people used it for wounds and infections for thousands of years.

What Makes Quality Tea Tree Oil
The best tea tree oil contains at least 30% terpinen-4-ol. This compound kills germs. Good oil also has less than 15% of a compound called 1,8-cineole, which causes skin irritation.
Simple Quality Check:
- Smell: Fresh, medicinal scent (not rancid or weak)
- Color: Pale yellow to clear
- Price: Quality oil costs $15-30 per ounce
- Label: Should say "Melaleuca alternifolia" and show country of origin
Why Australian Oil Matters
About 90% of real tea tree oil comes from Australia. Cheaper oils from other countries often contain synthetic additives or different plant oils. These won’t work the same way and may cause unexpected skin reactions.
I always recommend checking if the oil is Australian-sourced. It’s worth paying more for the real thing.
What Health Benefits Does Science Actually Support?
Websites claim tea tree oil cures everything. Most of these claims aren’t backed by real studies. Focus on the three proven uses that actually work.
Studies prove tea tree oil works for acne, athlete’s foot, and minor cuts. A 5% tea tree oil gel cleared acne as well as benzoyl peroxide in clinical trials, but with less skin irritation.

The Three Proven Uses
1. Acne Treatment
Multiple studies show 5% tea tree oil gel reduces pimples2 significantly. It kills acne bacteria and reduces redness. Most people see some improvement in 3-8 weeks.
2. Athlete’s Foot Relief
A 10% tea tree oil solution helps clear athlete’s foot fungus. It works about as well as over-the-counter antifungal creams but takes longer to show results.
3. Minor Wound Care
Tea tree oil kills many harmful bacteria, including antibiotic-resistant strains. Use it diluted on small cuts and scrapes after cleaning with soap and water.
What Doesn’t Work (Despite Claims)
Don’t expect tea tree oil to cure:
- Serious infections (you need antibiotics)
- Hair loss (no real evidence)
- Internal health problems (never swallow it)
- Severe fungal infections (prescription drugs work better)
Many customers ask about these uses because they read about them online. Save your money and use proven treatments for these conditions.
Start With Realistic Expectations
Tea tree oil works slowly compared to prescription medicines. Think of it as gentle, gradual improvement rather than overnight results. If you need fast relief or have a serious condition, see a doctor first.
How Should You Use Tea Tree Oil for Skin Problems?
Most people use tea tree oil wrong and get skin burns. Pure tea tree oil on skin causes redness, burning, and irritation. Always dilute it and start with small amounts.
Never use pure tea tree oil on skin. Always mix 1-2 drops with 1 teaspoon of carrier oil like coconut or jojoba oil. Test on a small skin area first and wait 24 hours.

Simple Dilution Recipe (What Actually Works)
For Acne Spots:
- 1-2 drops tea tree oil
- 1 teaspoon carrier oil (coconut, jojoba, or sweet almond)
- Mix in small bowl
- Apply with cotton swab to pimples only
- Use once daily to start
For Athlete’s Foot:
- 5 drops tea tree oil
- 1 teaspoon carrier oil
- Apply to clean, dry feet twice daily
- Focus on between toes and affected areas
What to Do If Your Skin Gets Irritated
Stop using tea tree oil immediately if you get:
- Redness that lasts more than a few hours
- Burning or stinging sensation
- Rash or bumps
- Increased acne or breakouts
Wash the area with mild soap and water. Most reactions clear up in 1-2 days. If irritation continues, see a healthcare provider.
Money-Saving Tips
One small bottle of tea tree oil lasts 3-6 months with daily use because you only need tiny amounts. Buy a 0.5-1 ounce bottle to start. Larger bottles may go bad before you use them up.
Store your oil in a cool, dark place. Heat and light make it less effective and more irritating to skin.
Does Tea Tree Oil Really Work Against Fungi and Nail Problems?
Nail fungus and stubborn skin fungi resist many treatments. Prescription antifungals have side effects and cost a lot. Tea tree oil helps mild fungal infections but has limitations you should know about.
Tea tree oil helps with mild toenail fungus and athlete’s foot, but it works slowly and doesn’t cure severe infections. Expect 6-12 months of daily use for nail fungus, with about 20% complete cure rate.

Realistic Expectations for Fungal Infections
Toenail Fungus:
- Use 100% tea tree oil (undiluted) on nails only
- File affected nails weekly before applying
- Apply twice daily for at least 6 months
- Works best on mild infections (less than 50% of nail affected)
- Many people see improvement but not complete cure
Athlete’s Foot:
- Dilute as shown above (5 drops per teaspoon carrier oil)
- Apply to clean, dry feet twice daily
- Keep feet dry and wear breathable shoes
- Usually improves in 2-4 weeks
When Tea Tree Oil Won’t Be Enough
See a doctor if you have:
- Thick, yellow, or crumbly nails
- Fungal infection spreading to multiple nails
- Pain or signs of bacterial infection
- Diabetes or circulation problems
- No improvement after 3 months of consistent use
Prescription antifungals work faster and more reliably for severe cases. Sometimes combining tea tree oil with prescription treatment helps, but ask your doctor first.
Cost Comparison Reality Check
Tea tree oil treatment:
- Cost: $20-30 for 6-month supply
- Time: 6-12 months daily application
- Success rate: 20% complete cure, 60% improvement
Prescription oral antifungals:
- Cost: $200-400 (often covered by insurance)
- Time: 3-6 months
- Success rate: 70-80% complete cure
For mild cases or as maintenance after prescription treatment, tea tree oil makes sense. For severe infections, prescriptions work better despite higher upfront cost.
What Are the Real Risks and Side Effects?
People think "natural" means "safe" and use tea tree oil carelessly. This leads to poisoning, skin damage, and serious side effects. Know the real risks and how to avoid them.
Tea tree oil is poisonous if swallowed and causes skin irritation in about 5% of people. Just one teaspoon can cause serious poisoning in children. Keep it away from kids and pets always.

The Most Important Safety Rules
Never Swallow Tea Tree Oil
Even tiny amounts cause:
- Nausea and vomiting
- Confusion and dizziness
- Loss of muscle control
- Coma in severe cases
If someone swallows tea tree oil, call Poison Control immediately: 1-800-222-12223.
Keep Away From Kids and Pets
Children and pets are much more sensitive. What’s safe for adults can poison them. Store tea tree oil in a locked cabinet, not just up high.
Always Test First
Put diluted oil on your inner arm. Wait 24 hours. If you get any redness, burning, or itching, don’t use tea tree oil anywhere else.
Less Common But Serious Risks
Hormone Effects in Boys
Some young boys developed breast tissue after using tea tree oil products. This is rare but scary for parents. Don’t use tea tree oil on children under 12 without asking a pediatrician first.
Skin Sensitization
Some people become allergic to tea tree oil over time, even if they used it safely before. If you develop new reactions, stop using it permanently.
What Most People Can Use Safely
If you’re a healthy adult with normal skin, properly diluted tea tree oil is usually safe for short-term use. Problems mainly happen when people:
- Use it undiluted
- Apply it to large skin areas
- Use it for months without breaks
- Ignore early signs of irritation
Start with small amounts on small areas. Increase gradually only if you have no problems.
How Does Science Rate Tea Tree Oil’s Antimicrobial Power?
Marketing claims about tea tree oil killing germs sound too good to be true. Customers need honest information about what it actually does. Lab studies show strong germ-killing power, but real-world results are more modest.
Laboratory tests show tea tree oil kills many types of bacteria and fungi in test tubes. Human studies show modest but real benefits for acne and athlete’s foot, but it’s not as strong as prescription medicines.
What Lab Tests Actually Mean
Tea tree oil kills germs impressively in laboratory dishes. But your skin isn’t a lab dish. Real skin has:
- Natural oils that dilute the tea tree oil
- Beneficial bacteria that compete with harmful ones
- Different pH and temperature than lab conditions
- Barriers that limit how deep the oil penetrates
This explains why lab results look amazing but real-world results are more modest.
Evidence Quality: The Honest Truth
Most tea tree oil studies are small and short-term. A major review in 2015 rated the evidence quality4 as "low" because:
- Studies had too few participants
- Many didn’t compare to standard treatments properly
- Results varied widely between studies
- Some studies had design flaws
Newer studies are better designed, but we still need larger, longer trials to know exactly how well tea tree oil works.
Where the Evidence is Strongest
Good Evidence:
- Acne improvement (several decent studies)
- Athlete’s foot relief (consistent results)
- Killing germs in lab tests (very strong)
Weak Evidence:
- Nail fungus cure (mixed results)
- Dandruff treatment (limited studies)
- Wound healing speed (mostly lab studies)
No Good Evidence:
- Hair growth
- Internal infections
- Serious medical conditions
Bottom Line for Customers
Tea tree oil is a legitimate natural antimicrobial, but it’s not a miracle cure. Use it for mild conditions where you have time for gradual improvement. For serious infections or when you need fast results, prescription treatments work better.
When Should You Choose Alternatives to Tea Tree Oil?
Tea tree oil isn’t right for everyone or every situation. Using it when you shouldn’t can waste time and money on ineffective treatment. Know when other options work better or are safer.
Choose alternatives if you have sensitive skin, need fast results, are treating children, or have severe infections. Salicylic acid works faster for acne, and prescription antifungals are more effective for serious fungal infections.

Better Options for Common Problems
For Acne (Faster Results):
- Salicylic acid 2%5 – works in 2-4 weeks
- Benzoyl peroxide 2.5% – kills bacteria quickly
- Retinoids (prescription) – best long-term results
For Fungal Infections (More Reliable):
- Terbinafine cream – cures nail fungus in 70% of cases
- Clotrimazole – available without prescription
- Oral antifungals – work from inside out
For Sensitive Skin:
- Manuka honey – gentle wound healer
- Aloe vera – soothing anti-inflammatory
- Colloidal oatmeal – calms irritated skin
Who Shouldn’t Use Tea Tree Oil
Definite No:
- Pregnant or breastfeeding women
- Children under 12
- People with eczema or very sensitive skin
- Anyone allergic to plants in the myrtle family
Use Caution:
- Elderly people (thinner skin)
- People taking blood thinners
- Those with hormone-sensitive conditions
- First-time essential oil users
Cost-Effectiveness Reality
Tea tree oil makes sense when:
- You have mild acne or athlete’s foot
- You prefer natural treatments
- You have time for gradual improvement
- Prescription options are too expensive
Other treatments make more sense when:
- You need fast results (job interview, special event)
- The condition is severe or spreading
- You’ve tried tea tree oil for 2 months without improvement
- You keep getting skin irritation
Smart Shopping Tips
Don’t buy tea tree oil if:
- The price seems too good to be true (under $10 per ounce)
- The label doesn’t list the plant name (Melaleuca alternifolia)
- It claims to cure serious diseases
- The seller makes extreme health claims
Look for:
- Australian origin
- ISO quality certification6
- Clear ingredient lists
- Realistic health claims
When to See a Healthcare Provider
Stop experimenting with tea tree oil and see a doctor if:
- Your skin condition is getting worse
- You develop signs of infection (pus, red streaks, fever)
- The problem affects your daily life or confidence
- You’ve tried multiple treatments without success
Professional treatment often saves time and money compared to trying multiple home remedies.
Conclusion
Tea tree oil offers proven benefits for mild acne and athlete’s foot when properly diluted, but alternatives often work faster and more reliably for severe conditions or sensitive individuals.
-
Comprehensive scientific overview of Melaleuca alternifolia covering botanical classification, chemical composition, and biological activities from peer-reviewed research databases. ↩
-
Detailed clinical microbiology review examining tea tree oil’s antimicrobial properties, including specific studies on acne treatment effectiveness and mechanisms of action. ↩
-
Official poison control resource providing authoritative safety information about tea tree oil toxicity, symptoms of poisoning, and emergency contact procedures. ↩
-
Systematic review of randomized controlled trials evaluating tea tree oil’s efficacy and safety for human health applications, including quality assessment of existing research. ↩
-
Medical overview of tea tree oil benefits and risks from a trusted health information source, including evidence-based treatment recommendations. ↩
-
Official ISO standard specifying quality characteristics and testing methods for tea tree oil to ensure product authenticity and therapeutic effectiveness. ↩